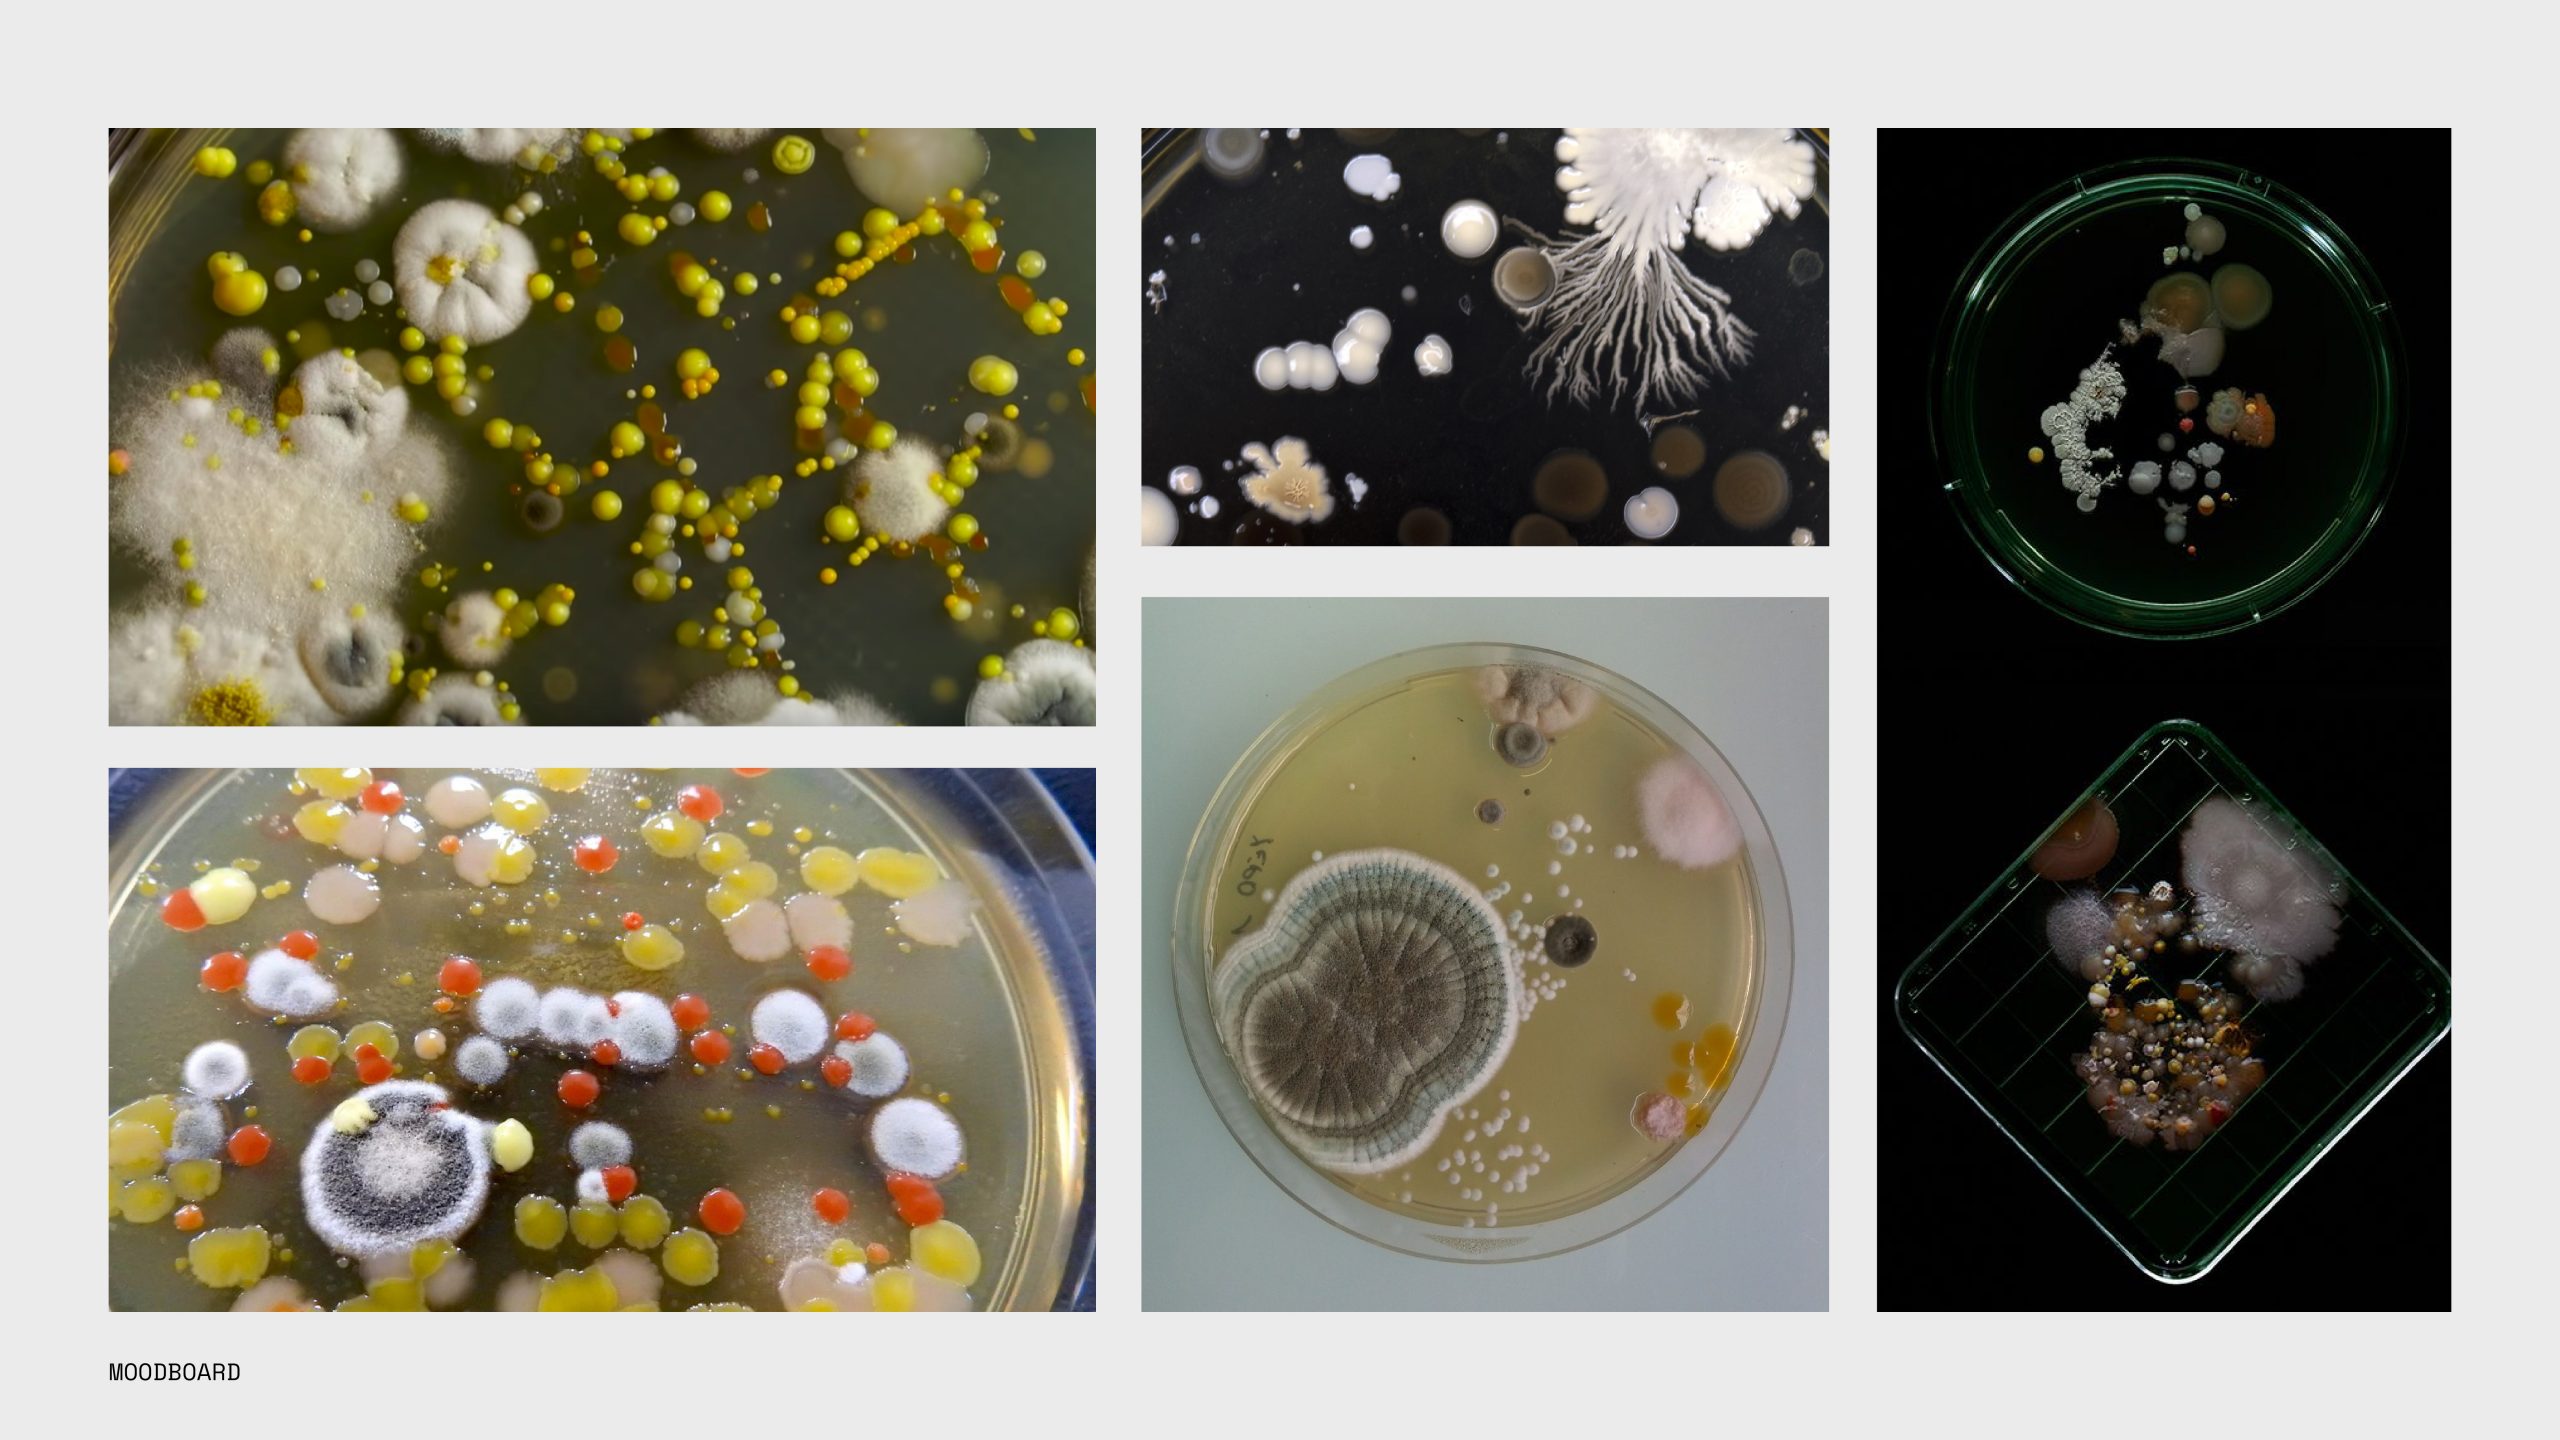

Culture Clash Branding Project
Culture Clash is an event that celebrates the intersection between art and biology. The name is an intentional pun which references cell cultures in the context of microbiology, but also the cultural differences between scientific and artistic communities.